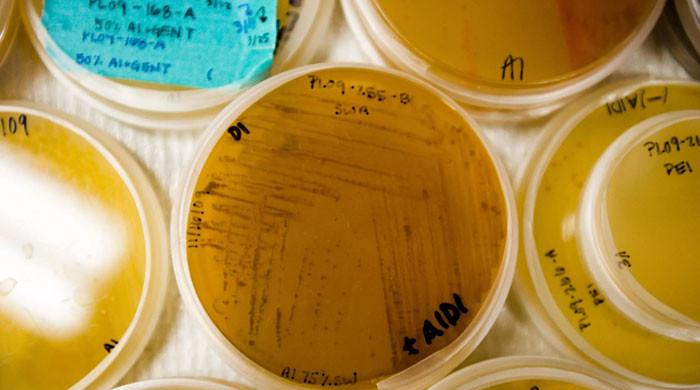

Read More Details
Finally We wish PressBee provided you with enough information of ( Scientists explore deep oceans for cancer treatment )
Also on site :
- Meta considered acquiring Perplexity before investing in Scale AI
- FDA approves breakthrough HIV prevention drug
- The No-Break-In Sneakers With a Notorious Waitlist Are Legitimately *So* Comfortable